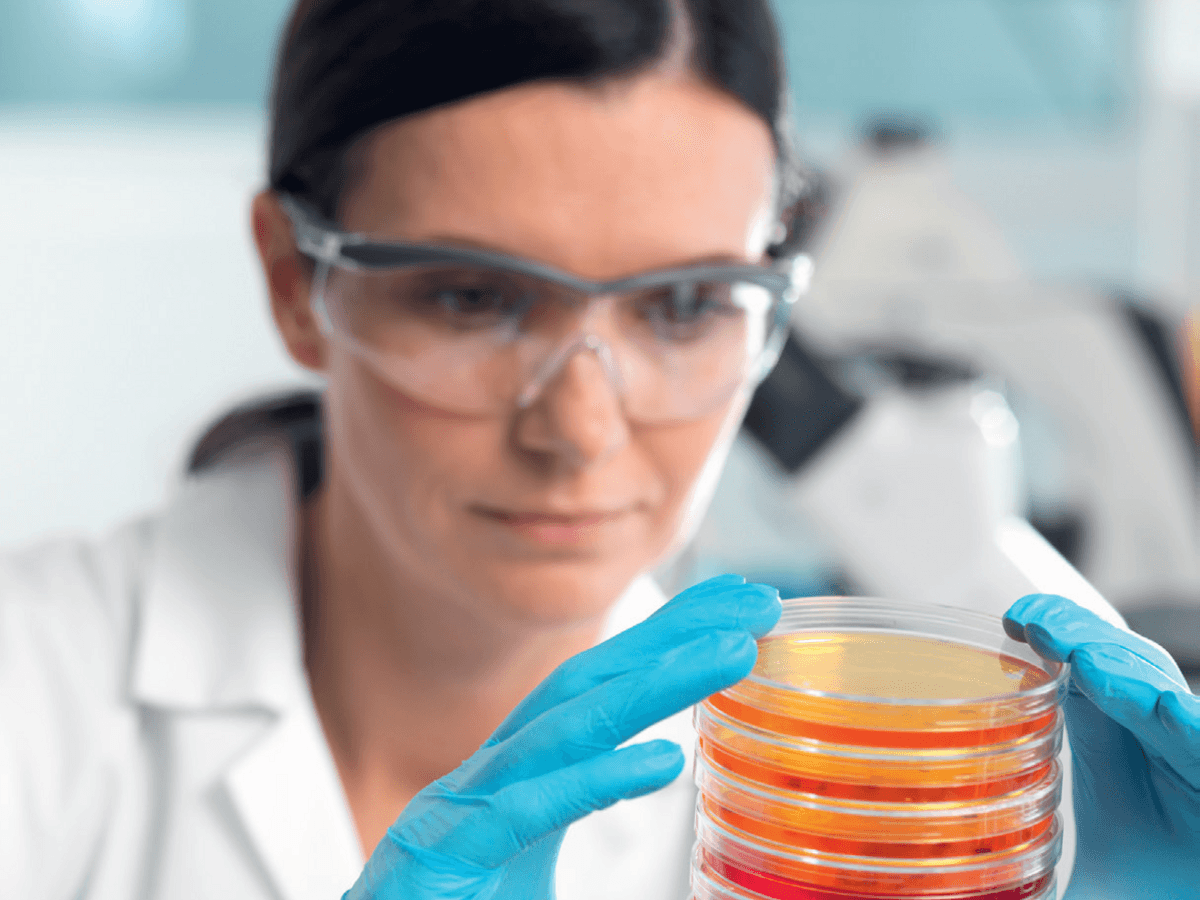
Bild på en person i labbkläder och handskar som håller i ett labbprov

Projekt ska undersöka förutsättningar av svenskt partnerskap för kliniska prövningar
Fem parter, Region Stockholm, Region Skåne och Västra Götalandsregionen, samt branschföreningarna Läkemedelsindustriföreningen och SwedenBIO, deltar i ett projekt med sikte mot partnerskap inom kliniska prövningar.
Vinnova har precis via det strategiska innovationsprogrammet Swelife, beviljat medel för en förstudie kring ett svenskt partnerskap för kliniska prövningar med särskilt fokus på företagsinitierade kliniska prövningar.
-Projektets parter är överens om att Sverige behöver höja ambitionsnivån för kliniska prövningar. Förstudien kommer därför att ta avstamp i att det, både utifrån ett tillväxt- och patientperspektiv, behöver genomföras fler kliniska prövningar i Sverige och i alla faser av terapiutvecklingen, säger Kristina Kannisto, forskningsstrateg i Region Stockholm.
Kliniska prövningar innebär möjligheter för patienter att redan i utvecklingsprocessen få tidig tillgång till nya, effektivare behandlingar samtidigt som de bidrar till hälso- och sjukvårdens utveckling. En ökning av kliniska prövningar stärker också life science-sektorn genom att prövningarna blir en viktig ingång för företag som investerar i forskning och produktion i Sverige.
Projektet projektleds ifrån Region Stockholm och koordineras av Region Skåne. Samtliga parter ansvarar för olika delar i projektet som förväntas resultera i:
- En ökad kunskap och beslutsstöd för prioritering av inom vilka behandlingsområden genomförandekapacitet av kliniska prövningar i Sverige, behöver stärkas.
- En förståelse för hur man på ett relevant och ändamålsenligt sätt kan reglera ett partnerskap så att det utformas och tydliggör respektive parts åtaganden.
- En modell för hur ett nationellt terapinätverk kan etableras och fungera över tid och samtidigt stärka Sveriges förmåga att genomföra kliniska prövningar.
- En fördjupad dialog med de danska och norska motsvarande partnerskapen (TrialNation och NorTrials) för best practice kring företagsinitierade, kliniska prövningar.
Projektet "Stärkt konkurrenskraft för kliniska prövningar" startade 1 april och pågår fram till sista juni 2025. Projektet bidrar till att uppfylla Region Stockholm framtagna handlingsplan för Kliniska prövningar och är även ett steg i att realisera Region Stockholms life science strategi
Håll dig uppdaterad! Prenumerera på nyheter du är intresserad av.
PrenumereraFler nyheter

Innovationsfonden 10 år: Årets innovation och årets implementeringsprojekt
Årets innovation och Årets implementeringsprojekt röstades fram av publiken på Innovationsfondens dag.
Kultur och innovation på Innovationsfondens dag
Under Innovationsfondens dag möts nytänkande idéer, föreläsningar och projekt som förbättrar vardagen för länets invånare.
Region Stockholm tar ett samlat grepp om Norra Hagastaden
Regionfullmäktige har nu beslutat om programdirektiv för Norra Hagastaden.